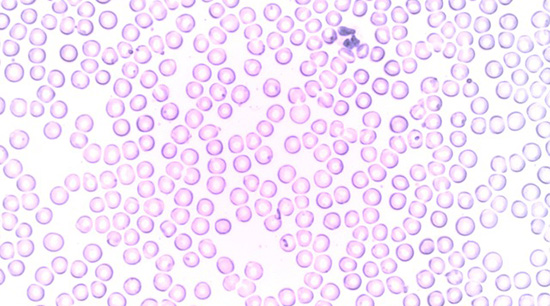
白細胞

我們平常不舒服、發燒的時候去做的“血常規”化驗,基本上就是為了看“白細胞”和“淋巴細胞”這兩個數值,聽說看這兩個數值,就能看出到底是不是有細菌或者病毒入侵、感染了人體,這是真的嗎?
白細胞、淋巴細胞,能基本判斷是否有感染
 細菌
細菌
在身體受到外部的細菌或者病毒來入侵的時候,我們身體的衛士——白細胞、淋巴細胞就會增加自己軍隊的數量,來抵抗外敵。所以,在有細菌或者病毒感染的時候,白細胞、淋巴細胞都會升高,我們可以通過這兩個數值,來基本判斷有沒有感染。
白細胞,不管是細菌、病毒都能對抗,但是如果白細胞裡面的分支——“中性粒細胞”升高了,一般就是細菌感染了;而如果白細胞的數量沒什麼變化,或者有所降低的時候,淋巴細胞的數量上升,這就說明可能是出現病毒的感染了。
血常規檢驗“感染”種類,並不完全準確
白細胞
白細胞
雖然在大多數情況下,血常規的確能幫我們判斷“感染”是什麼原因造成的,但也有特殊情況會出現。
1、白細胞數量降低,也可能是嚴重的細菌感染
如果細菌特彆強悍的話,白細胞不能完全應對這些“細菌”,而是大規模戰死沙場的話,白細胞的數量就會出現暫時性的降低,比如在流感的初期、或者是肺炎的時候,就會出現類似的狀況。
2、白細胞、中性粒細胞都增高,不一定是細菌感染
對於某些有免疫缺陷性疾病的人來說,即使沒有感染存在,白細胞、中性粒細胞的數量也會持續增高。
想要清楚是哪種“細菌”在搞鬼,可以做血培養
 化驗
化驗
在發燒的時候,如果治療效果不好,還想知道是哪種細菌造成了高熱,就可以用“血培養”的方法。它是把新鮮血液接種在營養培養基上,在一定溫度、濕度等條件下,細菌生長繁殖,就能對它進行鑑別了。
發燒初期,血常規判斷感染不好使
血常規在發燒、感冒的初期,並不能發揮“診斷”是細菌還是病毒感染的作用,入股發燒超過3天,這個時候檢驗血常規是比較有意義的。
血常規的檢驗結果,也並不是檢驗細菌、病毒感染的“金標準”,醫生要經過面診,結合病史和其他檢查,才能確定到底是什麼導致的發燒,進行相應的治療。
 互動百科公眾微信號
互動百科公眾微信號






























